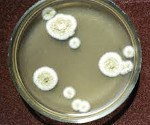

Другие названия и синонимы
B44 Aspergillosis, B44.
Описание
Аспергиллез вызывают споры грибков рода Aspergillus, которые присутствуют в пыли, почве и гниющих растениях. Возраст, пол, генетика, образ жизни пациентов для развития болезни значения не имеют.
|
|
Факторы риска
Споры безвредны для здоровых, но могут вызвать болезнь у людей с аллергической предрасположенностью, хроническими заболеваниями легких (такими как туберкулез или бронхоэктатическая болезнь) или при серьезном иммунодефиците.
У аллергиков эта инфекция проявляется в виде симптомов, похожих на астму. В уже пораженных другой болезнью легких эти грибки разрастаются в образования, называемые «грибковыми шарами», которые занимают полости, сформированные в ходе заболевания. Развивается кашель, иногда с кровавой мокротой. У пациентов с иммунодефицитом грибки могут поражать головной мозг. Для людей с нарушениями иммунной системы аспергиллез может быть смертельно опасен.
У аллергиков эта инфекция проявляется в виде симптомов, похожих на астму. В уже пораженных другой болезнью легких эти грибки разрастаются в образования, называемые «грибковыми шарами», которые занимают полости, сформированные в ходе заболевания. Развивается кашель, иногда с кровавой мокротой. У пациентов с иммунодефицитом грибки могут поражать головной мозг. Для людей с нарушениями иммунной системы аспергиллез может быть смертельно опасен.

Диагностика
Аспергиллез диагностируют по результатам анализа мокроты и серологическим анализам крови, указывающим на присутствие антител к этим грибкам. Проводят диагностическую флюорографию грудной клетки.
Лечение заключается в приеме противогрибковых лекарств, но иногда требуется хирургическое удаление «грибковых шаров».
Лечение заключается в приеме противогрибковых лекарств, но иногда требуется хирургическое удаление «грибковых шаров».